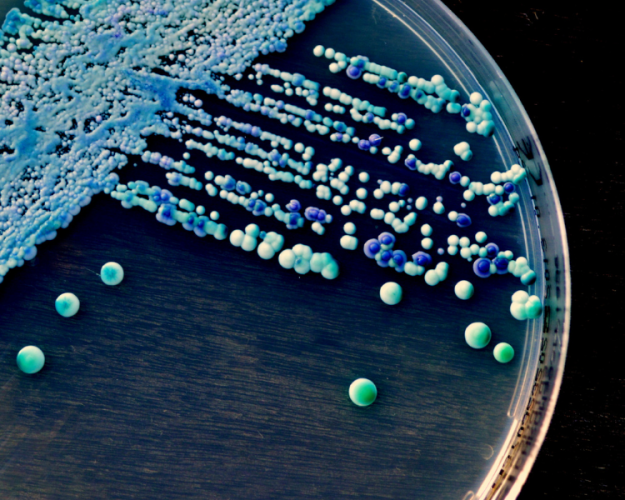

New rapid method: Detection of osmotolerant and/or osmophilic yeasts in just six days
Sep 29, 2025 - Foods
New rapid method: Detection of osmotolerant and/or osmophilic yeasts in just six days
New Rapid Method: Detection of Osmotolerant and/or Osmophilic Yeasts in Just Six Days
Starting September 15, 2025, the BAV Institute will offer a new accredited rapid method for the detection of osmotolerant and/or osmophilic yeasts. Qualitative results will be available in just six days, reducing the previous examination duration by four days.
Background
Osmotolerant and osmophilic yeasts can proliferate in sugary and low-water-content foods. For manufacturers of, for example, confectionery, fine bakery products, delicacies, and beverages, these microorganisms are a central topic of quality assurance. Accelerated detection helps companies identify risks early and quickly implement measures.
Advantages of the New Method
Results in six instead of ten days
Accredited, reliable test procedures
Identification of yeasts directly via MALDI-TOF
Germ count determinations remain unchanged at five days
Overview of Examination Methods
In addition to the new rapid method for yeasts, the BAV Institute uses a wide range of modern procedures to reliably address microbiological questions.
Parameter Examination Duration Examination Principle Accreditation
Salmonella 1 Day RT-PCR Yes
TentaSpeed Listeria spp. 6 Hours RT-PCR No
Listeria monocytogenes /
Listeria spp. 1 Day RT-PCR Yes
Cronobacter spp. 1 Day RT-PCR Yes
STEC/VTEC 1 Day RT-PCR Yes
Campylobacter spp. 2 Days Cultural Yes
Presumptive Bacillus cereus 1 Day Cultural Yes
Coagulase-positive
Staphylococci 1 Day Cultural Yes
Yeasts and Molds 3 Days Cultural Yes
Lactic Acid Bacteria 2 Days Cultural Yes
Presumptive Pseudomonads 2 Days Cultural Yes
Legionella 6 Hours RT-PCR No
Osmotolerant /
Osmophilic Yeasts 6 Days Cultural Yes
Germ Identification /
Strain Comparison 2-24 Hours MALDI-TOF Yes
With this combination of classic and accelerated methods, the BAV Institute supports companies in the food industry with safe and efficient microbiological quality control.
For questions, our customer advisors are happy to assist you. You may also directly contact Dirk Lorenz at: 0781-96 94 7-23 or via email at dirk.lorenz@bav-institut.de.
